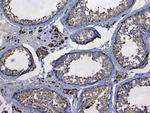
GSTM3 Antibody in Immunohistochemistry (Paraffin) (IHC (P))

Search
Invitrogen
GSTM3 Polyclonal Antibody
{{$productOrderCtrl.translations['antibody.pdp.commerceCard.promotion.promotions']}}
{{$productOrderCtrl.translations['antibody.pdp.commerceCard.promotion.viewpromo']}}
{{$productOrderCtrl.translations['antibody.pdp.commerceCard.promotion.promocode']}}: {{promo.promoCode}} {{promo.promoTitle}} {{promo.promoDescription}}. {{$productOrderCtrl.translations['antibody.pdp.commerceCard.promotion.learnmore']}}
图: 1 / 8
GSTM3 Antibody (PA5-79338) in IHC (P)

Please note: We are reviewing Western blot images included in the antibody testing data in our catalog, including those provided by third parties. Unless expressly labeled or annotated as “raw-unedited”, Western blot images included in the antibody testing data in our catalog may have been edited, optimized or otherwise adjusted for presentation.
产品信息
PA5-79338
种属反应
宿主/亚型
分类
类型
抗原
偶联物
形式
浓度
规格
纯化类型
保存液
内含物
保存条件
运输条件
RRID
产品详细信息
Reconstitute with 0.2 mL of distilled water to yield a concentration of 500 µg/mL.
Positive Control - WB: rat testis tissue, rat brain tissue, mouse testis tissue, mouse brain tissue, human Hela cell, human MCF-7 cell. IHC: human rectal cancer tissue, human lung cancer tissue, human testis tissue, mouse brain tissue, mouse testis tissue, rat brain tissue, rat testis tissue.
靶标信息
Glutathione S-transferase M3 (brain), also known as GSTM3, is an enzyme which in humans is encoded by theGSTM3 gene. Cytosolic and membrane-bound forms of glutathione S-transferase are encoded by two distinct supergene families. At present, eight distinct classes of the soluble cytoplasmic mammalian glutathione S-transferases have been identified: alpha, kappa, mu, omega, pi, sigma, theta and zeta. This gene encodes a glutathione S-transferase that belongs to the mu class. The mu class of enzymes functions in the detoxification of electrophilic compounds, including carcinogens, therapeutic drugs, environmental toxins and products of oxidative stress, by conjugation with glutathione. The genes encoding the mu class of enzymes are organized in a gene cluster on chromosome 1p13. 3 and are known to be highly polymorphic. These genetic variations can change an individual's susceptibility to carcinogens and toxins as well as affect the toxicity and efficacy of certain drugs. Mutations of this class mu gene have been linked with a slight increase in a number of cancers, likely due to exposure with environmental toxins.
仅用于科研。不用于诊断过程。未经明确授权不得转售。
篇参考文献 (0)
生物信息学
蛋白别名: Glutathione S-transferase GT9.3; Glutathione S-transferase Mu 3; GST class-mu 3; GSTM3-3; hGSTM3-3
基因别名: Fsc2; GST5; GSTM3; mGSTM5
UniProt ID: (Mouse) P19639
Entrez Gene ID: (Mouse) 14864




